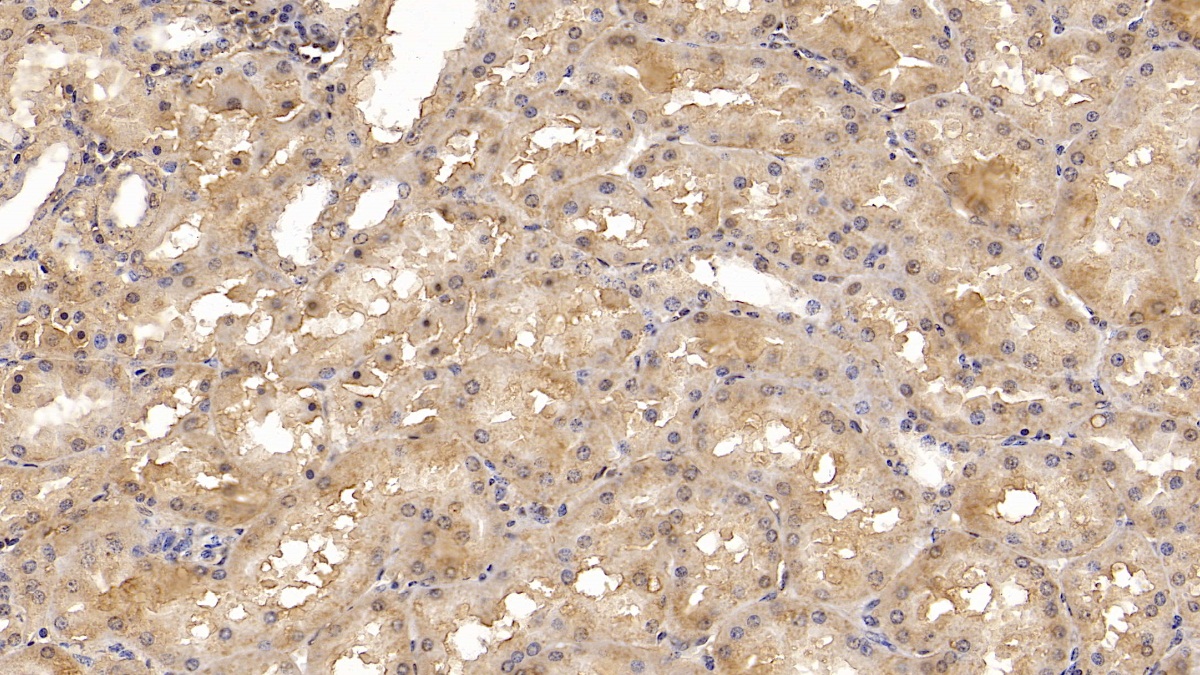

Monoclonal Antibody to Complement component 1 Q subcomponent-binding protein, mitochondrial (C1QBP) 

HABP1; GC1QBP; SF2p32; GC1Q-R; GC1qR; P32; Hyaluronan Binding Protein 1; Splicing Factor SF2-Associated Protein; ASF/SF2-associated p32
Overview
Properties
- Product No.MAA651Hu22
- Organism SpeciesHomo sapiens (Human) Same name, Different species.
- ApplicationsWB; IHC; ICC/IF; FCM
If the antibody is used in flow cytometry, please check FCM antibodies.
Research use only - DownloadInstruction Manual
- CategoryImmune molecule
- SourceMonoclonal antibody preparation, Host Mouse
- Ig Isotype IgG2a Kappa, Clone Number C3
- PurificationProtein A + Protein G affinity chromatography
- LabelNone
- Immunogen RPA651Hu01-Recombinant Complement component 1 Q subcomponent-binding protein, mitochondrial (C1QBP)
- Buffer FormulationPBS, pH7.4, containing 0.02% NaN3, 50% glycerol.
- TraitsLiquid, Concentration 1mg/mL
Sign into your account
Share a new citation as an author
Upload your experimental result
Review

Contact us
Please fill in the blank.
Specifity
The antibody is a mouse monoclonal antibody raised against C1QBP. It has been selected for its ability to recognize C1QBP in immunohistochemical staining and western blotting.
Usage
Western blotting: 0.5-3µg/mL
Immunohistochemistry: 5-30µg/mL
Immunocytochemistry: 5-30µg/mL
Optimal working dilutions must be determined by end user.
Storage
Store at 4°C for frequent use. Stored at -20°C in a manual defrost freezer for two year without detectable loss of activity. Avoid repeated freeze-thaw cycles.
Stability
The thermal stability is described by the loss rate. The loss rate was determined by accelerated thermal degradation test, that is, incubate the protein at 37°C for 48h, and no obvious degradation and precipitation were observed. The loss rate is less than 5% within the expiration date under appropriate storage condition.
Organism Species More: Rattus norvegicus (Rat)Giveaways
Increment services
-
 Antibody Labeling Customized Service
Antibody Labeling Customized Service
-
 Protein A/G Purification Column
Protein A/G Purification Column
-
 Staining Solution for Cells and Tissue
Staining Solution for Cells and Tissue
-
 Positive Control for Antibody
Positive Control for Antibody
-
 Tissue/Sections Customized Service
Tissue/Sections Customized Service
-
 Phosphorylated Antibody Customized Service
Phosphorylated Antibody Customized Service
-
 Western Blot (WB) Experiment Service
Western Blot (WB) Experiment Service
-
 Immunohistochemistry (IHC) Experiment Service
Immunohistochemistry (IHC) Experiment Service
-
 Immunocytochemistry (ICC) Experiment Service
Immunocytochemistry (ICC) Experiment Service
-
 Flow Cytometry (FCM) Experiment Service
Flow Cytometry (FCM) Experiment Service
-
 Immunoprecipitation (IP) Experiment Service
Immunoprecipitation (IP) Experiment Service
-
 Immunofluorescence (IF) Experiment Service
Immunofluorescence (IF) Experiment Service
-
 Buffer
Buffer
-
 DAB Chromogen Kit
DAB Chromogen Kit
-
 SABC Kit
SABC Kit
-
 Long-arm Biotin Labeling Kit
Long-arm Biotin Labeling Kit
-
 Real Time PCR Experimental Service
Real Time PCR Experimental Service